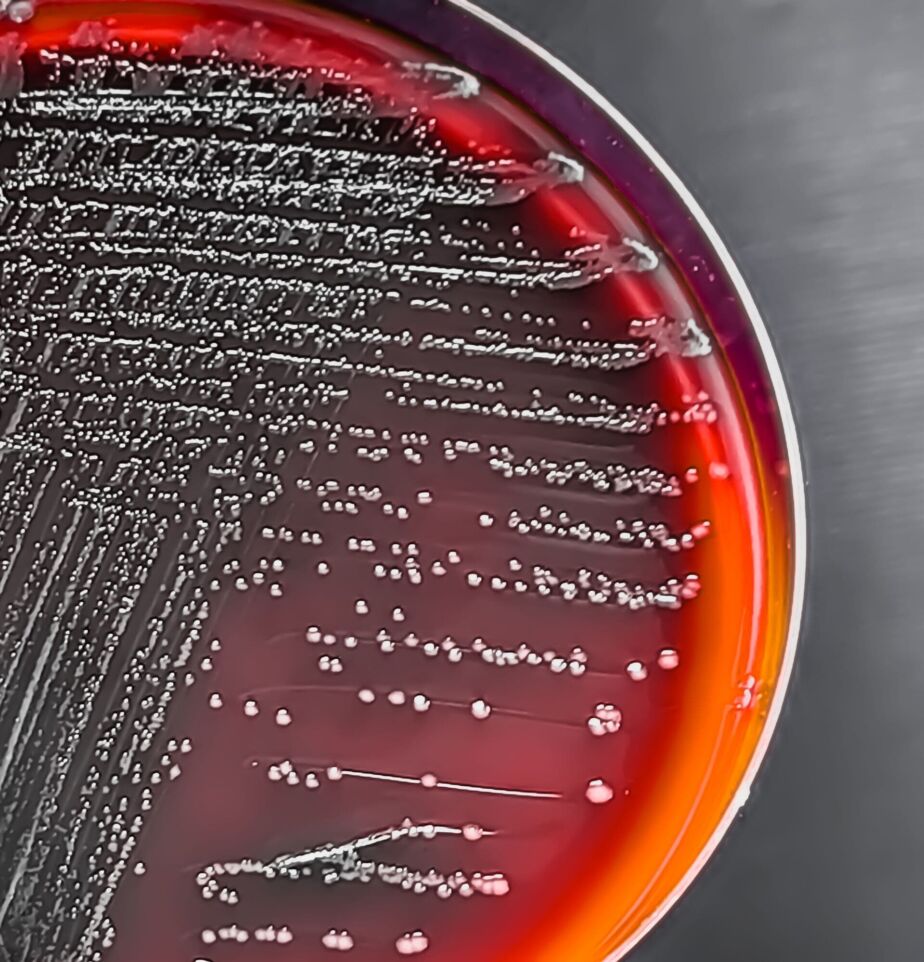

[ Innovative science ]
Don’t Be Next Target
Stay
Leading science that shapes patient futures
Protected.
Laboratory innovation
Driving smart health solutions
We deliver advanced tests and research that support better health for all.
We drive you to study, serve, and excel!


Science through innovation
We lead & inspire in modern healthcare fields
Pharma pioneers progress in science and healthcare by blending novel lab work, research, and pharmacy skills. We work in sync to boost care and enable new medical finds for a better world.
Driven by ethics, growth, and teamwork, our group aims for high standards in every step, with trust and bold ideas at the core of all we do.
Innovative science and pharmacy team
Pharma leads in lab, pharmacy, and research, raising standards and helping patients with new care and precise results.
Enabling progress in healthcare field
Our mission is to drive science and care with new ways, helping people and shaping the future.
Our promise of high standards daily
We value truth, growth, and skill, making sure our work always meets strict care and trust goals.
About Pharma and our vision today
Pharma leads in lab, drug, and research, shaping new care and raising the bar for health work.
Berlin
Hours
-
Mon-Fri 9:00AM — 4:00PM
Socials
Office locations

Have questions? Get in touch!
Need pharma support today?
Common questions answered
Pharma is committed to helping you access trusted lab and pharmacy solutions, with expert help at every step of the way.
How do I start with Pharma?
Contact us by email or phone to begin. Our team will organize a call to learn about your needs and tailor our help to you.
Can I book a remote consultation ?
Yes, we hold online meetings, connecting you with Pharma experts no matter where you are, for easy, fast support.
What sectors does Pharma cover?
We serve healthcare, labs, and research groups, providing services that match the unique needs of each client sector.
Do you support new ventures too?
We enjoy helping startups thrive! Our expert team guides new labs and firms as they launch and grow their projects.